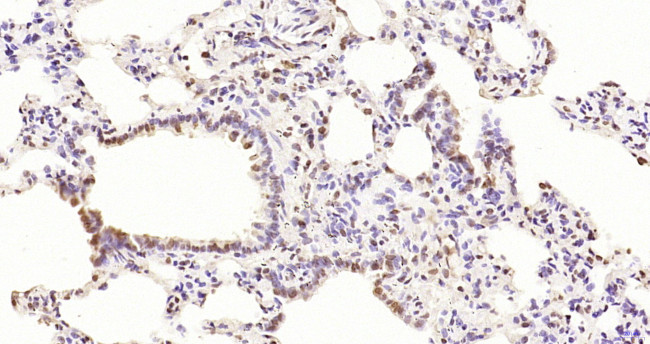
Phospho-PKC delta (Thr505, Thr507) Antibody in Immunohistochemistry (Paraffin) (IHC (P))

Search
Bioss
Phospho-PKC delta (Thr505, Thr507) Polyclonal Antibody
{{$productOrderCtrl.translations['antibody.pdp.commerceCard.promotion.promotions']}}
{{$productOrderCtrl.translations['antibody.pdp.commerceCard.promotion.viewpromo']}}
{{$productOrderCtrl.translations['antibody.pdp.commerceCard.promotion.promocode']}}: {{promo.promoCode}} {{promo.promoTitle}} {{promo.promoDescription}}. {{$productOrderCtrl.translations['antibody.pdp.commerceCard.promotion.learnmore']}}
图: 1 / 1
Phospho-PKC delta (Thr505, Thr507) Antibody (BS-3727R) in IHC (P)

产品信息
BS-3727R
种属反应
宿主/亚型
分类
类型
抗原
偶联物
形式
浓度
规格
纯化类型
保存液
内含物
保存条件
运输条件
靶标信息
The PKC family of serine/threonine kinases, including PRKCD (PKC delta), is activated intracellularly by signal transduction pathways. In humans, at least 12 different PKC polypeptides have been identified. These isoforms differ in primary structure, tissue distribution, subcellular localization, mode of action in vitro, response to extracellular signals, and substrate specificity. PKC alpha, beta I, beta II, and gamma form the conventional family; their activities are Ca2+- and phospholipid-dependent. Protein kinase C (PKC) can be activated by calcium and the second messenger diacylglycerol. PKC family members phosphorylate a wide variety of protein targets and are known to be involved in diverse cellular signaling pathways. PKC family members also serve as major receptors for phorbol esters, a class of tumor promoters. Each member of the PKC family has a specific expression profile and is believed to play distinct roles in cells. The protein encoded by this gene is one of the PKC family members. Studies both in human and mice demonstrate that this kinase is involved in B cell signaling and in the regulation of growth, apoptosis, and differentiation of a variety of cell types. Alternatively spliced transcript variants encoding the same protein have been observed.
仅用于科研。不用于诊断过程。未经明确授权不得转售。
篇参考文献 (0)
生物信息学
蛋白别名: 1-May; kinase nPKC-delta; KPCD; nPKC-delta; PKCdeltaVIII; Protein kinase C delta type; protein kinase C delta variant IX; protein kinase C delta VIII; protein kinase C, delta IV; protein kinase C, delta V; protein kinase C[d]; Tyrosine-protein kinase PRKCD; unnamed protein product
基因别名: AI385711; ALPS3; CVID9; D14Ertd420e; MAY1; nPKC-delta; PKC[d]; PKCD; PKCdelta; PRKCD
UniProt ID: (Human) Q05655, (Mouse) P28867, (Rat) P09215
Entrez Gene ID: (Human) 5580, (Mouse) 18753, (Rat) 170538